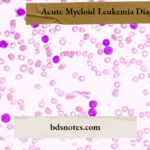
Acute Myeloid Leukemia Diagnosis

Acute Myeloid Leukemia (AML): Clinical Features and Diagnostic Insights Question. Write a short note on the clinical features and diagnosis of acute myeloid leukaemia. Answer. Clinical Features of acute Myeloid leukaemia It occurs in adults, and it ages range from 15 to 40 years. It accounts of 20% of childhood leukaemia. Symptoms due to anemia, i.e. … [Read more...] about Acute Myeloid Leukemia (AML): Clinical Features and Diagnostic Insights
General Medicine
Hemolytic Anemia: Causes, Symptoms, Diagnosis, and Treatment Explained
Hemolytic Anemia: Causes, Symptoms, Diagnosis, and Treatment Explained Question. Define and classify anemia. Discuss clinical features, investigation, and treatment of hemolytic anemia. Answer. It is defined as an acute disease marked by a deficiency or absolute lack of granulocytic WBCs, i.e., neutrophils, basophils, and eosinophils. Hemolytic Anemia Clinical … [Read more...] about Hemolytic Anemia: Causes, Symptoms, Diagnosis, and Treatment Explained
Asthma Prevention Tips: How to Avoid Common Triggers
Asthma Prevention Tips: How to Avoid Common Triggers Question. Write a note on the prevention of bronchial asthma. Answer. A disease of airways produced by hyperresponsiveness of the tracheobronchial tree to a wide variety of stimuli, resulting in reversible narrowing of air passage. Preventive Measures for Bronchial Asthma. Pollen Try to avoid exposure to … [Read more...] about Asthma Prevention Tips: How to Avoid Common Triggers
Lobar Pneumonia Complications: Pulmonary, Cardiac, and Systemic Effects
Lobar Pneumonia Complications: Pulmonary, Cardiac, and Systemic Effects Question. Mention the complications of lobar pneumonia. Answer. Complications of Pneumonia In lung: lobar pneumonia. Pleural effusion Pneumothorax Empyema Lung abscess Respiratory failure. In cardiac involvement: lobar pneumonia. Pericarditis Endocarditis Myocarditis … [Read more...] about Lobar Pneumonia Complications: Pulmonary, Cardiac, and Systemic Effects
Tetralogy of Fallot: Symptoms, Diagnosis, and Treatment Explained
Tetralogy of Fallot: Symptoms, Diagnosis, and Treatment Explained Question. Write short note on tetralogy of Fallot. Answer. It is the commonest cyanotic congenital heart disease in children above the age of 2 years. It is characterized by four constituents: Ventricular septal defect. Pulmonary stenosis Overriding or dextroposed aorta Right ventricular … [Read more...] about Tetralogy of Fallot: Symptoms, Diagnosis, and Treatment Explained